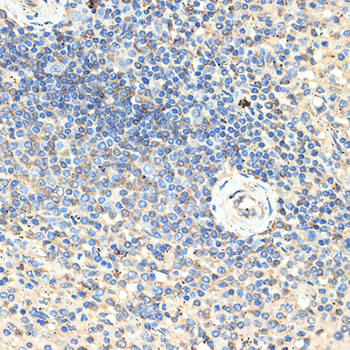

相关产品推荐更多 >
万千商家帮你免费找货
0 人在求购买到急需产品
- 详细信息
- 文献和实验
- 技术资料
- 免疫原:
Recombinant protein of human CD70
- 亚型:
IgG
- 形态:
液体
- 保存条件:
-20℃
- 克隆性:
Polyclonal Antibody
- 适应物种:
Human Mouse Rat
- 保质期:
1年
- 库存:
888
- 供应商:
北京索莱宝科技有限公司
- 宿主:
Rabbit
- 应用范围:
WB IHC IF
- 靶点:
CD70
- 规格:
50ul
| 英文名称 | Anti-CD70 Polyclonal Antibody |
| 中文名称 | 肿瘤坏死因子配体超家族成员7抗体 |
| 别名 | CD27-L;CD27L;CD27LG;TNFSF7;TNLG8A |
| 背景资料 | The protein encoded by this gene is a cytokine that belongs to the tumor necrosis factor (TNF) ligand family. This cytokine is a ligand for TNFRSF27/CD27. It is a surface antigen on activated, but not on resting, T and B lymphocytes. It induces proliferation of costimulated T cells, enhances the generation of cytolytic T cells, and contributes to T cell activation. This cytokine is also reported to play a role in regulating B-cell activation, cytotoxic function of natural killer cells, and immunoglobulin sythesis. |
| Swiss Prot | P32970 |
| Gene ID | 970 |
| 亚细胞定位 | Cell membrane |
| 宿主 | Rabbit |
| 克隆类型 | Polyclonal Antibody |
| 亚型 | IgG |
| 蛋白分子量 | 21/23kDa |
| 稀释比例 | WB 1:500-1:2000. IF 1:50-1:200. |
| 免疫原 | Recombinant protein of human CD70 |
| 纯化方法 | Affinity purification |
| 储存液 | Buffer: PBS with 0.03% Proclin300, 50% glycerol, pH7.3. |
| 保存 | Store at -20°C. Avoid freeze / thaw cycles. |
| 交叉反应 | Human Rat Mouse |
| 应用 | WB IF IHC |
| 规格 | 50ul 100ul |
| 单位 | 支 |
备注:
以上数据均来自公开文献, Solarbio暂未进行独立验证, 仅供参考。
These protocols are for reference only. Solarbio does not independently validate these methods.
温馨提示:
使用前请离心。如有问题请及时联系我们。
Quick spin before use. If you have any questions, please contact us.
实验图

Western blot analysis with CD70 antibody diluted at 1:1000;Lane:Rat brain,Rat spleen,Rat thymus
Immunohistochemistry of paraffin-embedded Human spleen with CD70 antibody diluted at 1:100

Immunofluorescence analysis of Jurkat using CD70 antibody diluted at 1:100
风险提示:丁香通仅作为第三方平台,为商家信息发布提供平台空间。用户咨询产品时请注意保护个人信息及财产安全,合理判断,谨慎选购商品,商家和用户对交易行为负责。对于医疗器械类产品,请先查证核实企业经营资质和医疗器械产品注册证情况。
 文献和实验
文献和实验Polyclonal Antibody Production
, if desired this is best accomplished by Protein A Affinity Chromatography. 上一篇:make an Antibody against a Peptides 下一篇:Immunization Protocol for Monoclonal Antibody Production
Polyclonal Antibody Production
Polyclonal Antibody Production Very useful for rapid and simple generation of antibodies for western blots, ELISA assays, and immunoprecipitation. Rabbit Immunization Initial Preparation Your antigen
a simple ELISA method to detect human anti-antibody response.
 技术资料
技术资料暂无技术资料 索取技术资料










